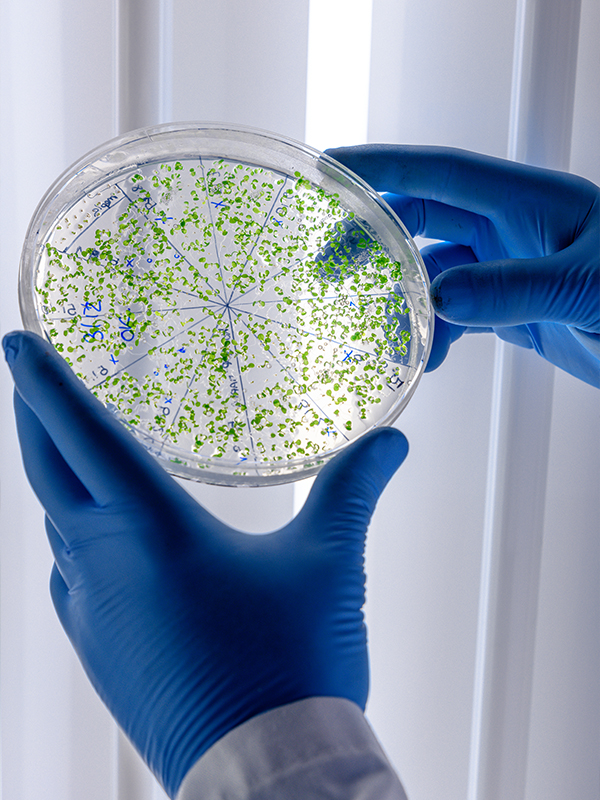

Services
Accurate, Fast & Accredited Food Testing Services
Accurate, Fast & Accredited Food Testing Services
NPRA-compliant herbal extract assay for both raw materials and finished products.
Quantified using Malaysia Herbal Monograph, China Pharmacopoeia and other validated standards.
Ensure your product meets regulatory requirements — contact us now for more information.


Ensure accurate nutritional labeling in compliance with Malaysia and International standards. Ideal for F&B products requiring certified nutrition panels for packaging and export.
Essential for health, safety and international quality standards.

To ensure food safety, hygiene, and regulatory compliance. Helps prevent spoilage, extend shelf life, and protect consumers’ health.
Comprehensive analysis of sugar types and content.


Measures individual amino acids in product to assess protein quality and support product claims.
|
|
|
Quantification of essential vitamins to ensure product meets nutritional standards and label claims
|
|


Detection and measurement of key minerals to support health claims and regulatory compliance.
|
|
Available for Accelerated and Real-Time Testing
|
|

We cover a wide range of products, including:
*For product categories not specified above, kindly contact us for advisory support

We offer free on-site or off-site sample collection within the Klang Valley. For locations outside the Klang Valley, kindly contact our office for further arrangements and assistance.
The standard turnaround time for analysis is 5 to 7 working days from the date we receive and register the sample.
The remaining sample is usually kept for 30 days in case retesting or verification is needed. After that, it may be discarded according to our laboratory’s policy. If you would like to keep the remaining, please inform us in advance.